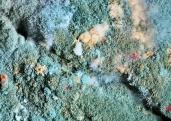
Article thumbnail

Institutul de Investigare a Crimelor Comunismului și Memoria Exilului Românesc a transmis un mesaj public de solidaritate cu Institutul Național pentru Studierea Holocaustului din România „Elie Wiesel”, pe fondul escaladării recente a manifestărilor antisemite din spațiul public. IICCMER califică episoadele din ultimele zile drept „inacceptabile și regretabile” într-o societate care se revendică de la valori democratice.
În comunicatul instituției se arată că este „absolut inadmisibil” ca memoria victimelor Holocaustului și comunitățile evreiești să fie ținta unor atacuri publice, mai ales într-un context marcat de tensiuni politice. IICCMER condamnă „cu fermitate” manifestările antisemite și valul de mesaje de ură care au inundat platformele online.
Reprezentanții institutului cer combaterea și sancționarea tuturor gesturilor iresponsabile și jignitoare, subliniind că doar prin respect și responsabilitate poate fi construită o societate dreaptă și conștientă de propria istorie.
Explozie de mesaje antisemite pe rețelele sociale
Poziția IICCMER vine după ce Institutul „Elie Wiesel” a avertizat că, în ultimele 48 de ore, manifestările antisemite „au explodat” pe rețelele de socializare, iar instigările ar fi atins „un nivel de violență maxim”. Potrivit institutului, valul de mesaje a fost alimentat de tensiunile generate de dezbaterea și votul din Parlament asupra modificărilor legislative privind sancționarea antisemitismului și a ideologiilor extremiste.
INSHR-EW arată că pretextul reacțiilor virulente îl reprezintă pozițiile exprimate din zona opoziției parlamentare după un incident petrecut în plenul Camerei Deputaților. Deputatul Silviu Vexler, reprezentant al comunității evreiești, a rupt un colaj cu mai multe personalități ale culturii române, asociate cu texte sau poziționări antisemite, gest care a amplificat conflictul simbolic din timpul dezbaterilor.
Momentul s-a produs într-o ședință tensionată, în care inițiatorul proiectului legislativ a fost întrerupt și contestat, iar parlamentari ai opoziției au afișat portrete ale unor autori canonici, transformând discuția într-o confruntare între ideea de „cultură” și cea de „propagandă”.
Incidentul din plen și reacțiile ulterioare
În timpul dezbaterilor, Silviu Vexler a îndepărtat afișul lipit în zona tribunei, iar după ce acesta a fost reaplicat, l-a mototolit și l-a rupt. Ulterior, deputatul și-a cerut scuze pentru gest, explicând că reacția a venit pe fondul tensiunilor din sală.
Într-o altă relatare publică, Vexler a susținut că a fost provocat și intimidat, afirmând inclusiv că ar fi fost amenințat. Potrivit acestuia, incidentul s-a produs într-o atmosferă ostilă, care a depășit cadrul unei dezbateri parlamentare normale.
Institutul „Elie Wiesel” consideră că transformarea reprezentantului comunității evreiești într-o țintă a unei campanii de ură, cu instigări explicite, are un efect de intimidare asupra întregii comunități și creează un precedent periculos în spațiul public.
Miza legislativă: sancțiuni mai dure pentru extremism
Contextul imediat al disputelor îl reprezintă votul asupra legii care modifică cadrul normativ de combatere a extremismului, inclusiv OUG nr. 31/2002 și Legea nr. 157/2018. Noile prevederi înăspresc pedepsele pentru organizații și materiale fasciste, legionare, rasiste sau xenofobe, precum și pentru negarea sau minimalizarea Holocaustului, inclusiv în mediul online.
Camera Deputaților a adoptat proiectul de lege la reexaminare cu 173 de voturi „pentru”, 106 „împotrivă” și șase abțineri, după ce președintele României, Nicușor Dan, retrimisese actul normativ în Parlament. Senatul votase forma transmisă mai departe pe 8 decembrie 2025, potrivit fișei legislative.
Dezbaterile au scos la iveală clivaje profunde în discursul politic, dar și o polarizare accentuată în spațiul public, reflectată rapid în reacțiile de pe rețelele sociale.
Protest în fața Templului Coral și apel la responsabilitate
În mesajul său, INSHR-EW mai semnalează că, de Ziua Minorităților Naționale din România, un grup de protestatari s-ar fi strâns în fața Templului Coral din București. În filmări publicate online s-ar fi auzit huiduieli și scandări antisemite, inclusiv mesaje de tipul „afară cu voi”.
Institutul avertizează că astfel de manifestări depășesc sfera libertății de exprimare și intră în zona instigării la ură, cu potențial de violență. În acest context, INSHR-EW solicită autorităților „maximă responsabilitate” în gestionarea situației.
Atât INSHR-EW, cât și IICCMER subliniază că solidaritatea publică în fața unor asemenea derapaje reprezintă un test al maturității societății românești și al capacității sale de a-și asuma lecțiile trecutului.

Comentează